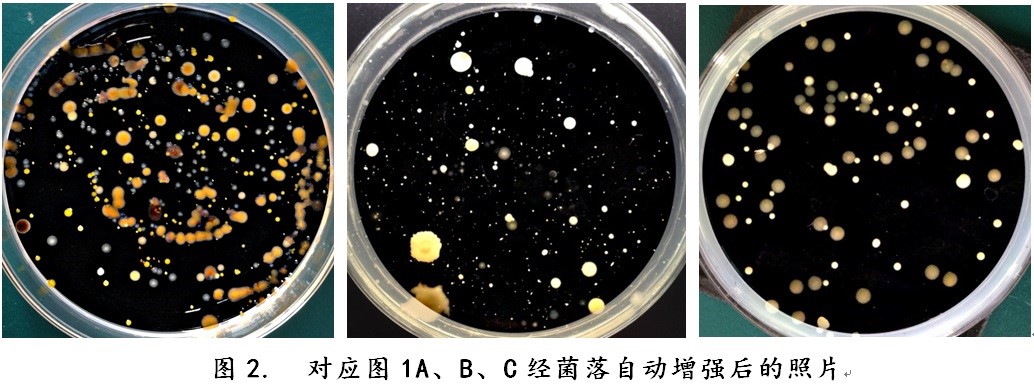
點擊查看大圖

萬深檢測科技發布HiCC-D 型2平皿全自動菌落計數分析儀新款
wseen 2016-1-20 10:43:27
有效實現2960萬像素光學分辨率自動聚焦的均勻背光、暗視野2平皿彩色自動成像和自動菌落計數。配有500萬像素拍照平板電腦,便于隨手拍實現全自動計數菌落,使用更便捷。適合50~180mm傾注、3M紙片、膜濾、涂布、螺旋平皿及相應矩形平板。

萬深檢測科技為考驗創新的自動菌落計數技術有效性,在日常開放式光照環境下,僅用手機拍攝的菌落照片來做全自動計數性能評測。評測對象包括:傾注法、涂布法、螺旋接種法、濾膜、3M測試片培養的各種菌落,包括花形的霉菌菌落,且對紙培養基或濾膜還允許有不同顏色、大小的網格線。
新發布的HiCC-D 型2平皿全自動菌落計數分析儀新款沿用了萬深智能化的菌落自動增強技術。自動區分菌落目標與非菌落的背景,是有效進行自動菌落計數的核心點。圖1、2、3顯示了萬深該創新技術對用手機拍攝的菌落照片自動矯正增強效果和自動計數標記結果。
無痕剔除網格及文字技術在HiCC-D 型2平皿全自動菌落計數分析儀也體現得非常完美。3M紙培養基或濾膜上存在的網格線,沒影響對菌落的自動計數,其自動計數標記詳見下圖:

相對于6平皿自動計數分析菌落的萬深HiCC-G型而言,HiCC-D 型2平皿掃描成像時間更短、價格也更低,其特別適合乳品行業中自動分類計數帶網紋3M紙片培養的極微小菌落。
更多信息,請訪問http://www.wseen.com/ProductDetail.aspx?id=25&classid=27 或聯絡萬深檢測科技,電話 0571-89714590 / Email:hzwseen@163.com